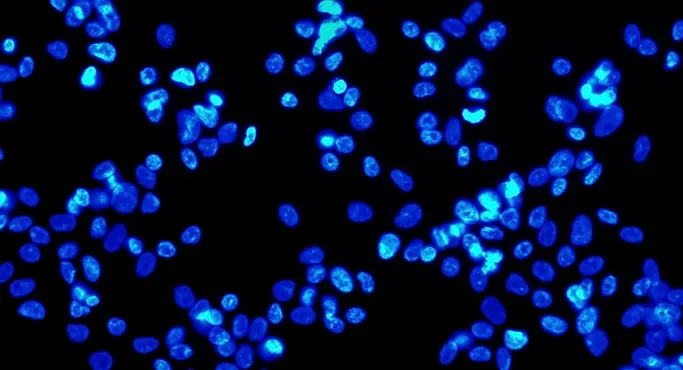
Noble Nobel Mice Series: Turn Back the Clock for Me: The Power of Pluripotent Stem Cells

Noble Nobel Mice Series: Turn Back the Clock for Me: The Power of Pluripotent Stem Cells
As a young biologist, I was fascinated with the mechanisms that, very early in development, lead a bundle of identical pluripotent stem cells to develop into hundreds of kinds of specialized cells that work together to create the human body. I found it remarkable that, though stem cells all have the exact same genetic material, some turn into neurons, some into hepatocytes, others into cardiac muscle cells, etc., by turning off specific sets of genes.
The idea of using the patient’s own cells to regenerate tissue for therapeutic purposes has fueled great enthusiasm to the medical field for the past several decades. The success of coaxing a patient’s cells to regenerate his or her own failing body parts, would solve the problem of the limited number of compatible organ donors. Until the 1960s, scientists thought that life was a one way street – that once cells differentiate, they lose their pluripotency, their ability to convert into different types of specialized cells and form different tissues.
In 1962, John B. Gurdon, a young embryologist challenged this idea and proved it wrong. He used the nucleus of a mature intestinal cell from a tadpole to replace the nucleus of a frog’s egg, creating the first cloned animal. His experiments showed that the specialization of cells is reversible: As it turned out, the genetic material from the tadpole’s mature intestinal cells had the potential to develop into all types of cells in the body of the frog.
It wasn’t until 44 years later that Dr. Shinya Yamanaka induced mature mouse cells to turn into pluripotent stem cells. He did this without having to transfer a nucleus from one cell into another. The trick to Yamanaka’s success was to introduce genes for only four transcription factors – Oct3/4, Sox2, Klf4 and c-Myc – into cultured fibroblasts. The resultant induced pluripotent stem (iPS) cells developed into a diversity of specialized cells, such as neurons and gut cells.
Dr. Yamanaka generated iPS cells by virally transducing certain transcription factors into non-pluripotent cells, forcing them to express certain genes. The iPS cells are similar to natural pluripotent in many ways: they express stem cell genes and proteins, exhibit the same DNA methylation patterns, and have the same doubling times as stem cells. For many years after Yamanaka’s success, scientists continued reprogramming somatic cells of different organisms – including humans- into iPS cells by using a four-gene combination of eitherOct4 (Pou5f1), Klf4, Sox2, and c-Myc. or Oct4, Sox2, Nanog, and Lin28. Several inducible mouse models have been developed in 2010 where the somatic expression of these reprogramming factors allows multiple somatic cell types to be directly reprogrammed to generate induced pluripotent stem cells (iPSCs).
In 2012, The Nobel Prize in Physiology or Medicine 2012 was awarded jointly to Dr. Gurdon and Dr. Yamanaka “for the discovery that mature cells can be reprogrammed to become pluripotent.” The groundbreaking discoveries of these two men have radically changed our vision how cells develop and specialize. They led to additional research that has shown that iPS cells can give rise to all the cell types of the body. Importantly, iPS cells circumvent the ethical constraints associated with embryonic stem (ES) cells and, because they are derived from the patient’s own cells, reduce the possibility of tissue rejection.
A few decades ago, the idea of using someone’s skin cells to produce their own brain or blood cells was the topic of good science fiction books and movies. Today, several research teams can obtain fibroblasts from patients with several diseases, reprogram them into brain cells to understand disease mechanisms, explore therapeutic treatments, and perform cell replacement therapy. It is very exciting that advances in the area of stem cell research have paved the way forclinical trials to treat disorders from hair loss to a variety of hematological malignancies.
